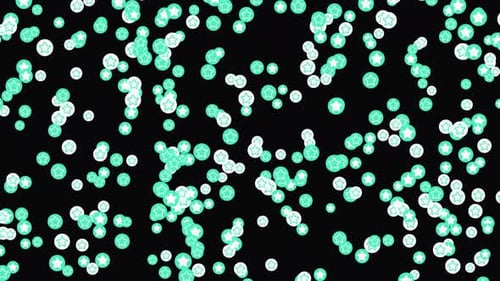
Falling Stars and Circles Flat Design Loop Background

Animated Flat Design Stars in Blue Circles Background
By IncrediVFXOne great value subscription from $16.50/month
- Unlimited downloads of 27+ million creative assets
- AI Tools: video, image and more
- Lifetime commercial license
- Easy cancellation
- Length
- 0:28
- Resolution
- 3840 x 2160
- File Size
- 418 MB
- Frame Rate
- 60 fps
- Alpha Channel
- No
- Looped
- Yes
- Video Encoding
- H.264
- Orientation
- Horizontal
- Commercial License
- Further Information
Description
This animated visual effect presents a vibrant and continuous looping pattern, ideal for energetic and playful projects. Bright yellow five-pointed stars are precisely encased within bold blue circles, which are meticulously arranged in a neat, repeating grid that seamlessly fills the entire frame. Each star performs a subtle, rhythmic rotation, creating a gentle, twinkling shimmer that adds dynamic interest to the otherwise flat and graphic design. The background beneath the blue circles features a soft, light pink hue adorned with delicate smaller pink dots, further enhancing the cheerful and graphic aesthetic. This clean, modern, and engaging animation serves as an excellent versatile background or overlay for a wide range of content, including children's videos, educational presentations, lively social media posts, or any digital project requiring a cheerful, inviting, and continuously moving visual element to capture attention and convey a sense of fun. Its simplistic yet captivating motion ensures it can enhance your visuals without distracting from primary content, making it a valuable tool for content creators.